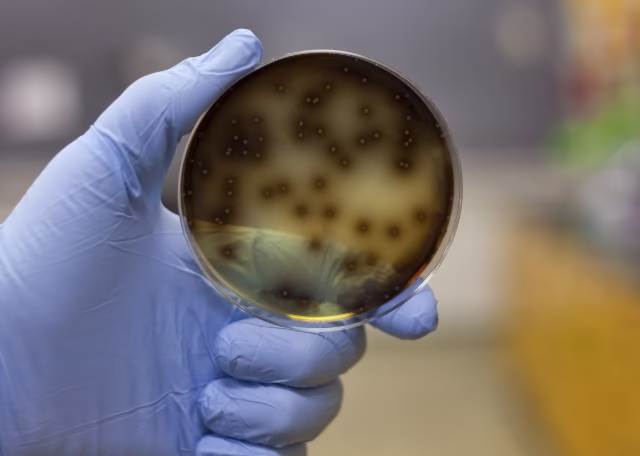

Jak działa dezynfekcja?
Dezynfekcja Katowice to proces, w którym usuwa się z powierzchni lub pomieszczeń drobnoustroje, takie jak wirusy, bakterie i grzyby. W tym celu używa się specjalnych urządzeń oraz środków chemicznych, które niszczą struktury komórek drobnoustrojów, powodując ich śmierć. Dzięki temu eliminuje się potencjalne źródła zakażenia i zapobiega rozprzestrzenianiu się chorób.
W Katowicach działa wiele firm oferujących usługi dezynfekcji, które pomagają utrzymać higienę w różnego rodzaju obiektach. Od domów prywatnych, przez biura i sklepy, aż po szpitale i przedszkola. Jedną z takich firm jest Ratapest, która działa w mieście Katowice i okolicach już od kilkunastu lat. Dezynfekcja przeprowadzana jest profesjonalnie i skutecznie z troską o zdrowie ludzi i zwierząt, dlatego warto zainwestować w bezpieczeństwo swoje i swoich bliskich.
Dezynfekcja Katowice. Jakie obiekty wymagają dezynfekcji?
Dezynfekcja może być przeprowadzana w różnego rodzaju obiektach, w zależności od potrzeb i wymogów higienicznych. W Katowicach najczęściej dezynfekowane są:
- domy prywatne i mieszkania – zwłaszcza w przypadku osób, które chorują lub są nosicielami chorób zakaźnych. Dezynfekcja może również być przeprowadzana w celu zapobiegania zakażeniom lub w sytuacji zgonu domownika;
- biura, sklepy i galerie handlowe – w miejscach pracy i handlu zwiększa się ryzyko zakażeń, dlatego dezynfekcja w mieście Katowice jest szczególnie ważna w tych obiektach. Zabieg pomaga zminimalizować ryzyko zakażeń, ponadto zapewnia bezpieczeństwo pracownikom i klientom;
- szpitale, przychodnie, szkoły i przedszkola – w tych obiektach ryzyko zakażeń jest szczególnie wysokie, dlatego dezynfekcja jest tam niezbędna;
- kurniki – szczególnie jeśli chodzi o nowoczesne kurniki, w których nierzadko znajdują się tysiące sztuk drobiu. Sprawia to, że atakujące drób patogeny z łatwością znajdują nowych nosicieli. O tym dlaczego warto przeprowadzać dezynsekcję i dezynfekcję w kurnikach i o tym, co gryzie drób przeczytasz na blogu;
- samochody osobowe, firmowe, dostawcze, karetki pogotowia – w celu pozbycia się wszelkich drobnoustrojów oraz usunięcia nieprzyjemnych zapachów.

Masz problem z pluskwami? Nie czekaj, aż się rozniosą.
Zadzwoń i krótko opisz objawy. Podpowiemy, co dalej i jak przygotować się do dezynsekcji.
+48 533 644 334Dezynfekcja Katowice – jakie są korzyści?
Wiele drobnoustrojów jest niebezpiecznych dla człowieka i zwierząt domowych czy hodowlanych, dlatego w wielu przypadkach przeprowadzenie dezynfekcji staje się koniecznością.
Usługi zwalczające drobnoustroje przynoszą wiele korzyści – przede wszystkim dezynfekcja zapobiega rozprzestrzenianiu się wirusów i bakterii, dzięki czemu pomaga utrzymać bezpieczeństwo i zdrowie ludzi i zwierząt. Dezynfekcja Katowice przeprowadzana jest w sposób skuteczny i profesjonalny, co zapewnia pełne zadowolenie klientów.
Skuteczność zabiegu zależy od wielu czynników i ta wielość czynników sprawia, że dezynfekcja Katowice jest skomplikowanym i wymagającym dużej wiedzy zabiegiem. Prawidłowo przeprowadzony zabieg uzależniony jest między innymi od:
- rodzaju zwalczanych mikroorganizmów i drobnoustrojów;
- ilości użytego środka chemicznego i jego stężenia;
- warunków zewnętrznych otoczenia (wilgotność, temperatura, poziom PH);
- obecności różnego rodzaju zanieczyszczeń.
Sprzątanie po zgonie w mieście Katowice
Odkażanie miejsc zgonu to nie lada wyzwanie. Nie jest to łatwe i przyjemne zadanie, a dodatkowo obarczone dużym ryzykiem wynikającym z obecności groźnych wirusów, bakterii i patogenów. Samodzielne sprzątanie po zmarłym jest bardzo niebezpieczne, dlatego na pomoc warto wezwać profesjonalną firmę DDD, która wykona kompleksową usługę.
Rozkładające się zwłoki to doskonałe warunki dla rozwoju różnego rodzaju mikroorganizmów, dlatego konieczne jest profesjonalne sprzątanie. Jednym z jej elementów jest właśnie dezynfekcja, która pomoże usunąć wszelkie drobnoustroje i patogeny zagrażające naszemu zdrowiu.
Ozonowanie jako naturalna metoda dezynfekcji
Ozon to doskonały środek dezynfekcyjny o wyjątkowo silnym działaniu odkażającym. Ozonowanie często stosowane jest w miejscach, w których doszło do powstania nieprzyjemnych zapachów, na przykład w samochodach lub w mieszkaniach osób palących papierosy. Sprawdza się doskonale jako element kompleksowej usługi sprzątania po zgonach, ponieważ na skutek rozkładu ciała wydzielane są bardzo nieprzyjemne zapachy.
Dezynfekcja Katowice przy użyciu ozonu pozwala na odkażanie pomieszczeń bez użycia chemii, stąd określenie „naturalna metoda dezynfekcji”. Dezynfekcja poprawia jakość powietrza, sterylizuje pomieszczenie, usuwa nieprzyjemne zapachy, eliminuje wszelkie drobnoustroje i patogeny oraz likwiduje alergeny. Doskonale radzi sobie z pleśnią, dlatego ozonowanie sprawdza się podczas odgrzybiania mieszkań.
Dlaczego warto zlecić dezynfekcję firmie Ratapest?
Mieszkasz w Katowicach lub okolicach i szukasz firmy zajmującej się dezynfekcją? Bardzo dobrze trafiłeś! Technicy z firmy Ratapest są specjalistami w branży DDD. Dezynfekcja, zaraz obok deratyzacji i dezynsekcji, jest jedną z kluczowych usług oferowanych przez naszą firmę. Zadzwoń i zamów bezpłatną wycenę!
Oferujemy dezynfekcję pomieszczeń, w tym mieszkań po zgonach, obiektów użyteczności publicznej, w tym banki, szpitale, przychodnie miejskie, kina i restauracje. Przeprowadzamy dezynfekcję pojazdów – samochody używane do wywozu odpadów, do transportu zwierząt, przewożących mięso, a także karetki pogotowia.
Firma Ratapest swoje usługi dezynfekcji świadczy od wielu lat i ma sprawdzone metody dostosowywane do okoliczności, w których doszło do skażenia. Korzystamy jedynie z atestowanych preparatów chemicznych oraz z najwyższej jakości sprzętu, w tym zamgławiaczy i ozonatorów. Zapraszamy do współpracy!